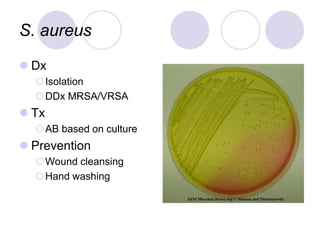
S. aureus
 Dx
Isolation
DDx MRSA/VRSA
 Tx
AB based on culture
 Prevention
Wound cleansing
Hand washing
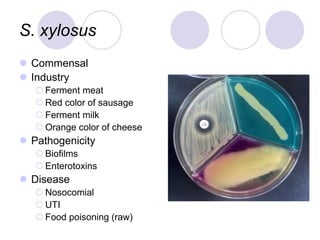
S. xylosus
 Commensal
 Industry
 Ferment meat
 Red color of sausage
 Ferment milk
 Orange color of cheese
 Pathogenicity
 Biofilms
 Enterotoxins
 Disease
 Nosocomial
 UTI
 Food poisoning (raw)

This document provides information on Staphylococcus bacteria. It discusses that there are over 61 Staphylococcus species, with important pathogenic species being S. aureus, S. epidermidis, S. saprophyticus, and S. pseudointermedius. It describes characteristics of Staphylococcus such as being low G+C content, clustering in grapelike formations, and producing catalase. Location, transmission, diseases caused, and virulence factors of several Staphylococcus species are summarized.